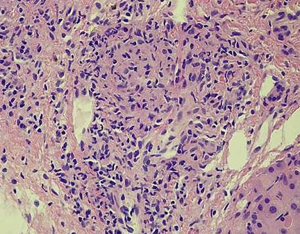

Hepatic nontuberculous mycobacterial granulomas in patients with cancer mimicking metastases: an analysis of three cases
Introduction
Hepatic granulomas can be observed in a variety of conditions, and the detection may indicate the first clue to an ongoing systemic disease. A hepatic granuloma is usually caused by Mycobacterium tuberculosis (MTB), rarely by nontuberculous mycobacteria (NTM) (1). The term “nontuberculous mycobacteria” (NTM) generally refers to mycobacteria other than MTB complex and M. Leprae (2). NTM are emerging pathogens that can affect both immunocompromised and immunocompetent people (3). Like MTB infections, NTM infections can occur anywhere in the body. It is classified into four clinical syndromes: chronic pulmonary disease, lymphadenitis, cutaneous disease, and disseminated disease (3,4). Hepatic nontuberculous infection can be a disseminated extrapulmonary expression of active NTM disease, with a tendency towards an increased incidence among people with underlying malignancy. Both tuberculous and nontuberculous infections of the liver in immunocompetent hosts are relatively rare, especially when they present as solitary or multiple nodules on imaging examinations, they are difficult to differentiate, frequently with misdiagnosis causing inappropriate therapy or delay in treatment (5-8). Herein, we describe three cases of hepatic granulomas caused by NTM infection occurring in patients with cancer, mimicking hepatic metastases on computed tomography (CT) and magnetic resonance imaging (MRI).
Case presentation
Case 1
A 49-year-old male reported to the hospital with multiple and various sizes of hypoechoic nodules in the right lobe of the liver during regular follow-up ultrasound surveillance after the operation. He had a personal history of ascending colon cancer and underwent right hemicolectomy half a year ago. The laboratory results of serum carbohydrate antigen-199 (2.7 ng/mL) and carcinoembryonic antigen (1.2 ng/mL) were all within normal limits. The other biochemical tests were nonspecific. Due to the findings of multiple hepatic nodules, subsequent CT examination was performed and demonstrated multiple, low attenuating nodules measuring 20–45 mm in size in S4–8 of the liver, no early enhancement in the arterial phase but slight peripheral enhancement in the portal venous phase (Figure 1A) after the administration of intravenous contrast agent. Fluorine-18 fluorodeoxyglucose positron emission tomography/CT (F-18 FDG PET-CT) revealed hepatic nodules are hypermetabolic (Figure 1B), highly suspecting metastases in the right lobe of the liver, considering personal colon cancer history. The patient received an ultrasound-guided fine needle biopsy (FNA) for tissue proof. Histopathological findings revealed granulomas with Langhans giant cells and infiltration of epithelioid and inflammatory cells, and the final diagnosis was a chronic inflammatory granuloma, while Ziehl-Neelsen staining and acid-Schiff staining showed negative for acid-fast bacilli and fungi. The polymerase chain reaction (PCR) for formalin-fixed paraffin-embedded tissue revealed NTM infection. The follow-up CT examination after three months showed no significant changes in previous hepatic granuloma and no newly appeared lesions.

Case 2
The second patient was a 58-year-old female with a history of right ovary clear cell adenocarcinoma and total abdominal hysterectomy and salpingo-oophorectomy were performed about 6 years ago. The routine follow-up imaging examinations showed no evidence of local tumor recurrence or distant metastases. The contrast-enhanced CT demonstrated multiple low attenuating lesions with peripheral enhancement in both lobes of the liver (Figure 2A) 3 years ago. The follow-up Gd-EOB-DTPA contrast-enhanced MRI revealed multiple hyperintensity nodules on the T2-weighted image (Figure 2B) with rim enhancement in the venous phase (Figure 2C) and without contrast agent uptake in the hepatobiliary phase (Figure 2D). Hepatic metastases were suspected after examinations, and FNA was performed on the nodule in segment S6 of the liver. Based on histopathology, the diagnosis was a hepatic granuloma, which was composed of epithelioid histiocytes and inflammatory cells without caseous necrosis. Then evaluation by NTM and MTB PCR kit showed positive for NTM infection and negative for MTB infection. The final diagnosis was a hepatic nontuberculous infectious granuloma, and antitubercular therapy was performed for 3 courses of treatment (21 days/1 course). In the subsequent three years of follow-up, the patient showed no significant changes of multiple hepatic granulomas and no newly developed lesions.

Case 3
The third patient was a 55-year-old male who had been diagnosed with rectal adenocarcinoma and bilateral renal cell carcinoma 2 years ago. Preoperative abdominal CT examination revealed an ill-defined, low attenuating lesion in segment S5 of the liver (measuring <1 cm). The laboratory examinations showed no obvious evidence of infection signs such as increased CRP level or WBC counting. Therefore, the initial diagnosis was focal fat deposition, and metastasis is less likely. Since the lesion was very small, no interventional treatments were administered, and a close follow-up was suggested. He underwent rectectomy and bilateral nephrectomy and sustained on long-term hemodialysis after the operation. However, the follow-up CT and MRI examinations in the half a year after the surgery revealed that the previous nodule in segment S5 of the liver increased in size from 1 to 2 cm with peripheral enhancement after administration of contrast agent (Figure 3). The F-18 FDG PET-CT demonstrated a hypermetabolic nodule in S5 of the liver, which indicated a high suspicion of hepatic metastasis. Finally, the successful FNA was done on this nodule of the liver. Microscopically, the nodule exhibited a caseating granuloma with a mixture of epithelioid histiocytes, inflammatory cells and Langhans giant cells in the background of fibrous tissue (Figure 4). Moreover, further NTM and MTB PCR kit revealed positive for NTM and negative for MTB. The patient received antitubercular treatment and was responsive to therapy. The latest follow-up CT showed the nodule decreased slightly from 2 to 1.4 cm in size and no other newly appeared lesions in the liver (Figure 3D).

Discussion
NTM are considered to be opportunistic environmental pathogens, not commonly causing diseases. However, under certain circumstances, NTM can cause a wide variety of infectious diseases, including pulmonary NTM disease, skin and soft tissue infection, musculoskeletal infection, lymphangitis, and disseminated infection, with the pulmonary involvement being the most common infection (9-13). NTM infections are typically related to immunocompromised conditions, such as AIDS/HIV infection, cancers, hematologic and solid organ transplantation, immunosuppressive therapy (14-16). However, there is a paucity of reports regarding hepatic NTM infection to date. It was reported that an old Japanese woman was suspicious of the liver tumor with a solitary, low-density lesion (17 mm in diameter) in S7 of the liver (17). The liver biopsy was performed, and histopathological examination revealed a caseating granuloma caused by Mycobacterium avium complex.
In our series of cases, the primary diagnoses were generally hepatic metastases. In the first and second patients, they were found with multiple variable-sized nodules, and the third patient manifested as a solitary nodule in the liver. The successful FNA was performed on one of the nodules in the first and second patient, and the isolated nodule in segment S5 in the third patient. Moreover, the definite diagnoses of three patients were obtained as hepatic nontuberculous granulomas. As the nontuberculous granulomas demonstrate overlapped imaging features with hepatic metastases, it is very hard to differentiate if only depending on CT or MRI imaging when they occurred in patients with malignancy. Because of the history of primary malignant tumors, the metastatic nodules could be the initial diagnosis or could not be excluded from for these three cases. Other differential diagnoses may include pyogenic abscess, cholangiocarcinoma, inflammatory pseudotumor and atypical hemangioma (18,19).
Since there is a scarcity of literature on imaging findings of hepatic nontuberculous granulomas, we summarized the radiological manifestations of hepatic NTM infections from three cases and the review of the literature on hepatic tuberculosis (20-22). In the first patient, there were two comparatively large hypoattenuating nodules (>2 cm in size) with slightly rim enhancement in the right lobe of the liver in portal venous phase on contrast-enhanced CT. The lesions that measure >2 cm in size are considered as the macronodular type (20). CT imaging features of hepatic macronodular granulomas depend on the compositions and stages of nontuberculous infections (23). Granulomas without caseation appear hypodense and generally display no enhancement or merely peripheral enhancement on enhanced CT. However, the imaging appearance of caseous granuloma can be variable and different. They may demonstrate multiple enhancing septations within necrosis, similar to pyogenic abscesses (20). In the second patient of our series, the lesions were multiple, generally less than 2 cm in size and tended to be randomly distributed or scattered across the liver parenchyma. The lesions appeared as hypodensity nodules in the form of small foci on CT and exhibited peripheral enhancement or without obvious enhancement on contrast-enhanced CT. The lesions showed hypointensity on T1WI images and slight hyperintensity on T2WI images. After administration of contrast agents (Gd-EOB-DTPA), the lesions demonstrated rim enhancement in the arterial and portal venous phase, and low signal intensity without Gd-EOB-DTPA uptake in the hepatobiliary phase (24). Regardless of the macronodular or miliary pattern, it can make it difficult to distinguish them from metastases, tuberculosis, or other forms of granulomatous diseases. The isolated lesion of the third patient was discovered before the operation. It presented as a solitary hypovascular nodule for 1 year and became larger after the operation. It appeared as a hypoattenuating or hypointensity nodule with minimal peripheral enhancement on contrast-enhanced CT or MRI. Based on the history of malignant tumors, it is extremely difficult to differentiate it from a single metastatic nodule.
Due to the similarity in imaging manifestations with hepatic tuberculosis or metastasis, hepatic NTM infection is often either misdiagnosed or labeled as indeterminate lesions. Misdiagnosis or delayed diagnosis of NTM infections can result in improper treatment or intervention, even serious morbidity and mortality (25,26). Liver biopsy should be the most specific diagnostic modality, which is indicated in anyone with a radiographic suspicion or exclusion of hepatic lesions (27).
Conclusions
We have described three rare cases of hepatic granulomas caused by NTM infection mimicking metastases in patients with cancer. The diagnosis could be difficult to make since the symptoms and imaging findings are nonspecific. Therefore, hepatic nontuberculous granuloma should be considered when imaging findings were controversial to clinical presentations, especially in patients with a history of malignant tumors. However, the final definite diagnosis is obtained through histopathologic and microbiological examinations.
Acknowledgments
Funding: This study was supported by the grants from the special scientific research project of National Chinese Medicine clinical research base of China (No. 2018JDZX004).
Footnote
Conflicts of Interest: The authors have no conflicts of interest to declare.
Ethical Statement: The study was approved by the Ethics Committee of all the hospitals and written informed consent was obtained from all patients.
References
- Coash M, Forouhar F, Wu CH, Wu GY. Granulomatous liver diseases: A review. J Formos Med Assoc 2012;111:3-13. [Crossref] [PubMed]
- Koh WJ. Nontuberculous mycobacteria-overview. Microbiol Spectr 2017;5. [Crossref] [PubMed]
- Chan ED, Iseman MD. Underlying host risk factors for nontuberculous mycobacterial lung disease. Semin Respir Crit Care Med 2013;34:110-23. [Crossref] [PubMed]
- Simons S, Van Ingen J, Hsueh PR, Van Hung N, Dekhuijzen PN, Boeree MJ, Van Soolingen D. Nontuberculous mycobacteria in respiratory tract infections, eastern Asia. Emerg Infect Dis 2011;17:343-9. [Crossref] [PubMed]
- Sonika U, Kar P. Tuberculosis and liver disease: Management issues. Trop Gastroenterol 2012;33:102-6. [Crossref] [PubMed]
- Kansal AP, Chopra V, Singh H, Singh U. Tubercular hepatic abscess--a rare presentation. Indian J Tuberc 2008;55:217-20. [PubMed]
- Wang X, Shi X, Yi C, Chen Z, Zhang B, Zhang X. Hepatic tuberculosis mimics metastasis revealed by 18F-FDG PET/CT. Clin Nucl Med 2014;39:e325-7. [Crossref] [PubMed]
- Kayar Y, Ekinci I, Turkdogan FT, Atay M, Soytas RB, Kayar NB. A rare case of isolated macronodular hepatic tuberculosis (Tuberculous) in an immunocompetent patient. J Pak Med Assoc 2015;65:1235-6. [PubMed]
- Lai CC, Hsueh PR. Diseases caused by nontuberculous mycobacteria in Asia. Future Microbiol 2014;9:93-106. [Crossref] [PubMed]
- Umrao J, Singh D, Zia A, Saxena S, Sarsaiya S, Singh S, Khatoon J, Dhole TN. Prevalence and species spectrum of both pulmonary and extrapulmonary nontuberculous mycobacteria isolates at a tertiary care center. Int J Mycobacteriol 2016;5:288-93. [Crossref] [PubMed]
- Hogan JI, Hurtado RM, Nelson SB. Mycobacterial Musculoskeletal Infections. Thorac Surg Clin 2019;29:85-94. [Crossref] [PubMed]
- Franco-Paredes C, Marcos LA, Henao-Martínez AF, Rodríguez-Morales AJ, Villamil-Gómez WE, Gotuzzo E, Bonifaz A. Cutaneous Mycobacterial Infections. Clin Microbiol Rev 2018;32:e00069-18. [Crossref] [PubMed]
- Drummond WK, Kasperbauer SH. Nontuberculous Mycobacteria: Epidemiology and the Impact on Pulmonary and Cardiac Disease. Thorac Surg Clin 2019;29:59-64. [Crossref] [PubMed]
- Ose N, Minami M, Funaki S, Kanou T, Kanzaki R, Shintani Y. Nontuberculous mycobacterial infection after lung transplantation: a report of four cases. Surg Case Rep 2019;5:11. [Crossref] [PubMed]
- Guglielmetti L, Mougari F, Lopes A, Raskine L, Cambau E. Human infections due to nontuberculous mycobacteria: the infectious diseases and clinical microbiology specialists' point of view. Future Microbiol 2015;10:1467-83. [Crossref] [PubMed]
- Henkle E, Winthrop KL. Nontuberculous mycobacteria infections in immunosuppressed hosts. Clin Chest Med 2015;36:91-9. [Crossref] [PubMed]
- Tamai Y, Tanaka H, Yoshikawa K, Sugimoto R, Higashitani K, Morooka R, Yamamoto N, Hasegawa H, Iwasa M, Takei Y. A case of a solitary Mycobacterium avium complex lesion of the liver. Nihon Shokakibyo Gakkai Zasshi 2016;113:1230-5. [PubMed]
- Wu Z, Wang WL, Zhu Y, Cheng JW, Dong J, Li MX, Yu L, Lv Y, Wang B. Diagnosis and treatment of hepatic tuberculosis: Report of five cases and review of literature. Int J Clin Exp Med 2013;6:845-50. [PubMed]
- Diallo I, Mbengue A, Gning SB, Amar MA, Ndiaye B, Diop Y, Fall F. MBaye PS. Hepatosplenic tuberculosis simulating secondary malignant lesions with cholangitis. BMC Res Notes 2016;9:316. [Crossref] [PubMed]
- Kakkar C, Polnaya AM, Koteshwara P, Smiti S, Rajagopal KV, Arora A. Hepatic tuberculosis: A multimodality imaging review. Insights Imaging 2015;6:647-58. [Crossref] [PubMed]
- Kumar P, Taneja S, Gupta K, Duseja A, Dhiman RK, Chawla YK. Unusual presentation of tubercular liver abscess in an immune-competent adult. J Clin Exp Hepatol 2017;7:77-9. [Crossref] [PubMed]
- Chou CK, Chou SC. Necrotizing granulomatous inflammation of the liver. Radiol Case Rep 2016;11:157-60. [Crossref] [PubMed]
- Yu RS, Zhang SZ, Wu JJ, et al. Imaging diagnosis of 12 patients with hepatic tuberculosis. World J Gastroenterol 2004;10:1639-42. [Crossref] [PubMed]
- Iguchi Hiroyoshi, Yamazaki Hitoshi, Tsunoda Hidekazu, Takahashi Yoshihito, Yokomori Hiroaki. A case of inflammatory pseudotumor of the liver mimicking hepatocellular carcinoma on EOB-MRI and PET. Case Rep Med 2013;2013:594254. [Crossref] [PubMed]
- Velayati AA, Rahideh S, Nezhad ZD, Farnia P, Mirsaeidi M. Nontuberculous mycobacteria in Middle East: Current situation and future challenges. Int J Mycobacteriol 2015;4:7-17. [Crossref] [PubMed]
- Yoon HJ, Choi HY, Ki M. Nontuberculosis mycobacterial infections at a specialized tuberculosis treatment centre in the Republic of Korea. BMC Infect Dis 2017;17:432. [Crossref] [PubMed]
- Hickey AJ, Gounder L, Moosa MY, Drain PK. A systematic review of hepatic tuberculosis with considerations in human immunodeficiency virus co-infection. BMC Infect Dis 2015;15:209. [Crossref] [PubMed]